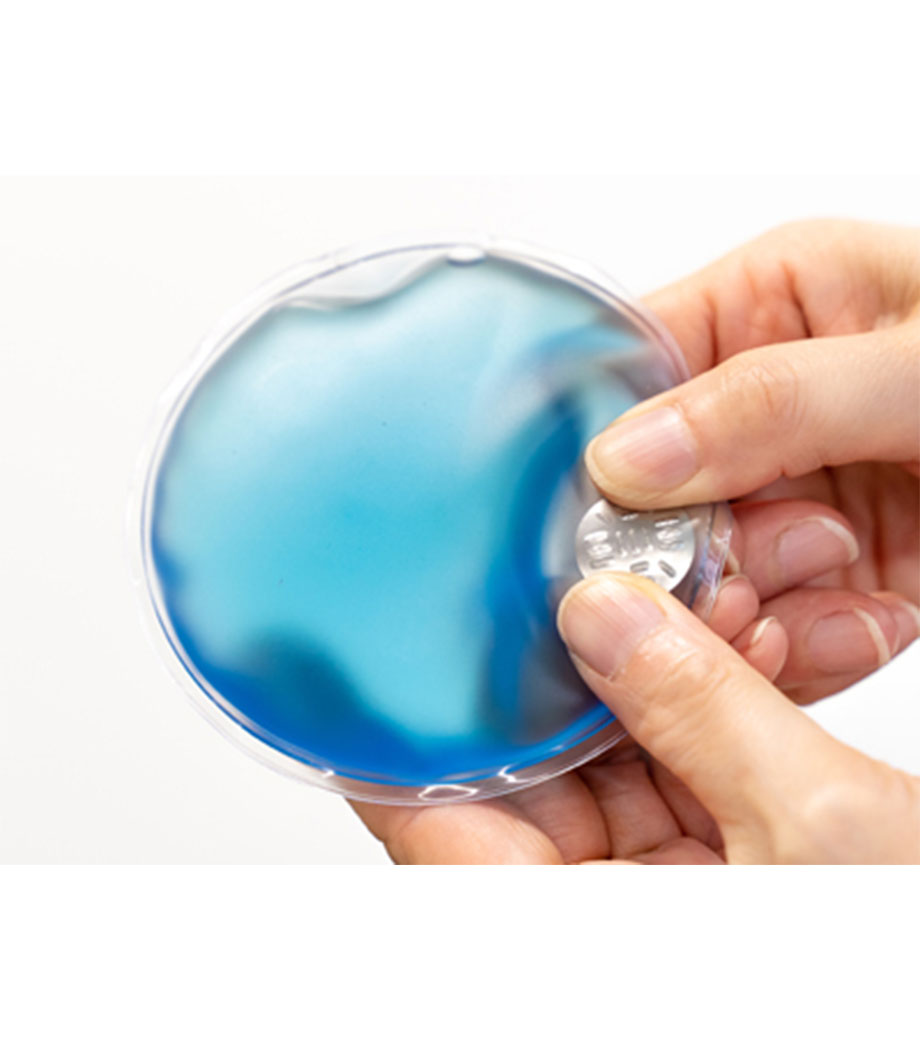

本体カラークリアの 商品一覧

小ロット10枚から作成可能!
OB-file-a4-4c-st
印刷代込み 46円(税込)~
最小発注数10個
オモテとウラの全面にフルカラー印刷が可能なクリアファイル。細かなデータや写真がきれいに表現できるので、デザインにこだわったオリジナルのノベルティを作成していただけます。
かさばらず実用的なクリアファイルは展示会で人気の販促品。定番のA4サイズはオフィス・学校・自宅、幅広いシーンで活躍するので、長い宣伝効果が期待できます。学校説明会の配布用資料入れとしても人気があり、集合写真を印刷すれば思い出に残る卒業記念品になります。


出荷日の目安
- 印刷あり
- 2026/04/08
- 商品のみ(印刷なし)


持ち運んで使うのに嬉しい抗菌仕様
LF-7740
623円(税込)
最小発注数30個
ALCLEA 抗菌クリップファイルは、本体とクリップカバー部分に抗菌素材を使用。ウイルスの増殖を抑えてくれるので、衛生的に使えて安心です。OPP袋入りでファイルに直接触れずに配布できます。A4サイズの用紙がしっかり収まる大きさなので、持ち運ぶ際に紙が折れてしまう心配がありません。立ちながらでも記入しやすいように、表紙を360°折り返すことができます。
表紙・内面・内ポケット部分に1色で名入れできます。表紙に大きくロゴや企業名を印刷すれば、貰った人の印象にも残りやすくなりますよ。内面や内ポケット部分にさりげなく名入れするのもオシャレですね。展示会や講演会などのイベントをはじめ、薬局やクリニックの内覧会のノベルティにもピッタリです。


出荷日の目安
- 印刷あり
- 2026/04/14
- 商品のみ(印刷なし)
- 2026/04/07


夜道の安全対策に!
V010601
86円(税込)
最小発注数30個
暗い夜道で車や自転車のライトを反射!運転手からの視認性を大幅に向上させ、事故防止に役立ちます。バッグやランドセル、自転車にキーホルダー感覚で簡単に取り付け可能。通勤・通学、夜間のウォーキングなど、子どもから大人まで幅広くご使用いただけます。
1色印刷・フルカラー印刷に対応しており、安全教室の記念品や防犯キャンペーンのノベルティに最適です。実用性の高いオリジナル安全グッズで、安心を届けませんか?
動画提供 : SELECTIONS


出荷日の目安
- 印刷あり
- 2026/04/14
- 商品のみ(印刷なし)
- 2026/04/01


ショッパーにおすすめ
MARU-90371300
251円(税込)
最小発注数30個
汚れや水に強くレジャーにも使いやすいPPクロス素材バッグです。ハンドルは肩掛け・手持ちできる2種類。広めの底マチでプラホック付き。中身が見えません。耐久性があり、重い荷物も楽々持ち運びできます。
オリジナルデザインでオシャレなバッグを製作できます。入会・購入特典など、ブランドロゴを印刷して長く使ってもらえるノベルティを作りませんか?クリア・ホワイト・ブラック・ブルー・ライトブラウンの5色から選べます。


出荷日の目安
- 印刷あり
- 2026/04/14
- 商品のみ(印刷なし)
- 2026/04/01


会社名・学校名を箔で名入れ
OB-file-a4-h
印刷代込み 29円(税込)~
最小発注数100個
キラキラと美しく輝く箔押し印刷対応のクリアファイル。半透明で中が透けて見えるので、内容物の確認に手間取りません。
かさばらず実用的なクリアファイルは展示会で人気の販促品。定番のA4サイズはオフィス・学校など幅広いシーンで活躍するので、資料やパンフレットを挟んで配布すれば長い宣伝効果が期待できます。箔押し印刷はワンポイントデザインで高級感を演出でき、学校説明会用の資料入れやスクールグッズとしても人気があります。


出荷日の目安
- 印刷あり
- 2026/04/10
- 商品のみ(印刷なし)


記念品やオリジナルグッズ制作に
H313943
469円(税込)
最小発注数30個
写真やイラストをプリントしたノベルティの制作にぴったりなグラスです。広範囲にフルカラー印刷できてインパクト抜群!ワンポイントで企業名やロゴの名入れも可能です。周年記念品や竣工記念品、ファンクラブグッズやキャラクターグッズなど、幅広い用途で活用いただけます。
容量は約330mlで缶ジュース1本程度。飲み口が広く大きめの氷を入れやすいのも特徴です。中身が透けて見えるクリアタイプ、すりガラスのような質感が楽しめるフロストタイプからお選びください。


出荷日の目安
- 印刷あり
- 2026/04/22
- 商品のみ(印刷なし)
- 2026/04/09


ウイスキーがわかる大人たちに
H099045
275円(税込)
最小発注数30個
ウイスキーやリキュールをストレートで楽しみたい方に、ぜひおすすめしたいのが「ショットグラス 50ml」。広口タイプで飲みやすい、シンプルなストレートグラスです。くつろぎの時間に永くご愛用いただけるので、オリジナルの記念品にも最適です。


出荷日の目安
- 印刷あり
- 2026/04/14
- 商品のみ(印刷なし)
- 2026/04/09


荷物の量で持ち方を変えられる
MARU-90371501
308円(税込)
最小発注数30個
ラミクロスバッグ 2WAYトートは強度がバツグンのPPクロス素材を使用しています。水に強く軽量で耐久・通気性がある優れものバッグです。汚れてもサッと拭けば綺麗になるから、お手入れが楽チンなのも人気の秘密。丈夫でマチが広くたっぷり収納できるので、ホームパーティーやアウトドアの大量買い出しにも大活躍ですよ。長さの違う持ち手は荷物の量によって使い分けできます。
エコバッグにランドリーバッグ、砂遊び用のおもちゃ入れなど様々な使い方ができます。1色印刷で広い範囲に名入れ可能です。オリジナルデザインで普段使いもできる、おしゃれバッグ製作に。イベントのノベルティや記念品、販促品として人気です。


出荷日の目安
- 印刷あり
- 2026/04/14
- 商品のみ(印刷なし)
- 2026/04/01


繰り返し使えるエコロジーなカイロ
V010567
121円(税込)
最小発注数30個
リサイクルエコカイロは繰り返し使えて環境にやさしいカイロ。中の金属片を数回パチパチ押し曲げると、ジェルが化学反応を起こし瞬時に温かくなります。暖かさは約30分持続します。使用後は熱湯で10分ほど煮沸し、冷水で冷やせば元通り。何度も再利用できます。
選べる3色展開で、1色の名入れ印刷が可能です。アウトドアやスポーツイベントのノベルティや、教育関係の合格祈願グッズにもおすすめです。
動画提供:SELECTIONS


出荷日の目安
- 印刷あり
- 2026/04/14
- 商品のみ(印刷なし)
- 2026/04/01


SDGsを意識したオリジナルグッズに
TS-1702
165円(税込)
最小発注数30個
EVAクリアポーチ(M)は、環境に優しいEVA素材。塩素を含まず、焼却してもダイオキシンが発生しません。水や紫外線に強く耐久性があるので、長くお使いいただけるノベルティが製作できます。スライダー部分は、フックに引っかけられるリング付き。かさばらないマチなしの形状で、配布しやすいのもポイントです。
シンプルなデザインで名入れが映えるので、企業名やブランドロゴを印刷すれば宣伝効果が高まります。ショップの購入特典や、イベントのオリジナルグッズにいかがでしょうか。


出荷日の目安
- 印刷あり
- 2026/04/14
- 商品のみ(印刷なし)
- 2026/04/01


持ち運びに便利なカラビナ付き
TS-0477
308円(税込)
最小発注数30個
クリアボトルは4色選べるカラーのカラビナ付きスポーツボトルです。硬化プラスチック製で、ぎゅっと握ってもへこみません。ボディにぐるっと大きな印刷が可能で、小ロットからオリジナルクリアボトルが制作できます。
容量は約500mlで、ペットボトル1本分と同じです。
バッグの持ち手などに引っ掛けて使えるカラビナ付きだから、携帯にとっても便利。スポーツを楽しんだあとの水分補給や、レジャーやアウトドアに気軽に連れていってください。
クリアブラック、レッド、ブルーにあえて同色系の印刷をすると、目立ちすぎないおしゃれな仕上がりになります。イラストやロゴをかっこよく印刷したい方にオススメのボトルです。デザインについて、是非お気軽にご相談ください。


出荷日の目安
- 印刷あり
- 2026/04/14
- 商品のみ(印刷なし)
- 2026/04/01


文字の上にも貼れる透明タイプ
NES3075
71円(税込)
最小発注数30個
パステルフィルム付箋は、5色の付箋フィルムを各20枚入りにしたセット。文字の上に貼っても、下の文字が透けて見える便利な透明タイプです。
ピッとつまんで取り出せるピックアップ式なので、必要な個所にささっと貼れます。大切なスケジュールに貼っておけば、うっかり忘れの防止に。スーツの胸ポケットにも入る、スリムで携帯しやすいプラケース入りなので、使いたい時にすぐに取り出せます。


出荷日の目安
- 印刷あり
- 2026/04/14
- 商品のみ(印刷なし)
- 2026/04/01


フタの開け閉めが簡単!
TS-0751
649円(税込)
最小発注数30個
「ステンレスタンブラー」は、アウトドアやオフィスに最適なシンプルで手頃なサイズのタンブラーです。保冷・保温にすぐれている二重構造なので、オールシーズン使え機能性抜群!丈夫なステンレス製なのも魅力的です。ふたはスライド式なので、飲まない時は飲み口を閉じておけます。


出荷日の目安
- 印刷あり
- 2026/04/14
- 商品のみ(印刷なし)
- 2026/04/01


推しカラーグッズ製作に!
TS-1181
352円(税込)
最小発注数30個
スリムクリアボトルはフルーツティーやアイスティーをおしゃれに持ち歩けるマイボトル。雑貨屋さんでも見かけるクリアボトルに、オリジナルのプリントができます。容量は約500mlで、飲み物だけでなく布製品や食品を入れるパッケージ用途にも人気です。
豊富なカラー展開で、「推しカラー」グッズ製作にもおすすめ!側面またはキャップに名入れ印刷が可能です。エンタメ関連のグッズ製作にはもちろん、飲食店や美容院の周年記念品などにいかがでしょうか。


出荷日の目安
- 印刷あり
- 2026/04/14
- 商品のみ(印刷なし)
- 2026/04/01


ドリンクが一気におしゃれに!
KD255017
418円(税込)
最小発注数30個
中に入れた飲み物が浮いたように見えるデザインが大人気のダブルウォールグラス。ホットドリンクも楽しめる耐熱タイプです。容量は約240mlで、コーヒーや紅茶を1杯楽しむのに丁度いいサイズ。二重構造だからアイスだと結露せず、ホットだとカップが熱くなりすぎず持ちやすいのがポイントです。広口設計で、デザートカップとしてもお使いいただけます。
グラス側面にオリジナル印刷が可能。カフェやバーの開店・周年記念品にいかがでしょうか。


出荷日の目安
- 印刷あり
- 2026/04/14
- 商品のみ(印刷なし)
- 2026/04/01


いつ起こるか分からない災害に備える
RM36025
383円(税込)
最小発注数30個
ソナえーる/防災ボトル6点セットは、バッグにいれておきやすい500mlのクリアボトル入り防災セット。ライト・アルミブランケットなど災害時の便利アイテム6点入りです。ボトルは水に強いので、常備薬・マスク・ガジェット用ケーブルなど濡れると困る物を入れておくのもおススメ!水分補給時にも役立ち、同梱の「防災ガイド」に連絡先を記入して入れておけば万が一の災害時も安心ですね。
ボトルに1色でロゴを名入れ可能です。地域の防災イベントや、子供会の記念品などにいかがでしょうか。


出荷日の目安
- 印刷あり
- 2026/04/14
- 商品のみ(印刷なし)
- 2026/04/01


オリジナルでおしゃれなグッズ制作!
KD197311
438円(税込)
最小発注数30個
3WAYビニルスパバッグはクリア素材とメッシュ素材の2つのバッグを重ねたスパバッグセットです。普段使いはもちろん濡れたものの持ち運びにも便利。温泉・プールへのお出かけの際に持ち込み用品をまとめたり、お家の化粧品や美容グッズの整理にも。フレキシブルに使えます。
印刷は1色印刷、フルカラー印刷からお選びいただけます。ロゴを印刷すれば、思わず持ち歩きたくなるおしゃれなノベルティの作成が可能です。美容関係・リラクゼーション・ネイルサロンの開店記念や周年記念・キャンペーンにおすすめです。


出荷日の目安
- 印刷あり
- 2026/04/14
- 商品のみ(印刷なし)
- 2026/04/01


通気性・耐久性が抜群!
MARU-90371101
337円(税込)
最小発注数30個
ラミクロスバッグ Mは強度がバツグンのPPクロス素材を使用しています。水に強く軽量で耐久・通気性がある優れものバッグです。長い持ち手は肩から掛けられます。2リットルのペットボトルが5本収納可能!重い荷物も楽に運べますよ。チャック付きでストレージバッグにも使え、次のシーズンまで使わないマリン用品や、保存食などの保管にも向いています。
エコバッグにランドリーバッグ、お子さまのおもちゃ入れなど様々な使い方ができるラミクロスバッグ。1色印刷で広い範囲に名入れ可能です。アパレルショップ・雑貨店のショッパー製作としても使えます。末永く愛用してもらえるノベルティとしていかがでしょうか。


出荷日の目安
- 印刷あり
- 2026/04/14
- 商品のみ(印刷なし)
- 2026/04/01


汎用性の高い業務用トールグラス
MST-20101HS
836円(税込)
最小発注数30個
ソフトドリンクからカクテルまで幅広く使える、満水量285mlのゾンビーグラス。ジャパンメイドの業務用商品です。安全性にこだわった強化ガラスを使用し、万が一割れても破片が広範囲に飛び散らない設計。口部はコールドカット加工で口当たりの良い飲み心地に仕上がっています。
側面にはオリジナル印刷が可能です。レストランやバーのロゴを入れてオリジナルグラス制作にいかがでしょうか。


出荷日の目安
- 印刷あり
- 2026/04/14
- 商品のみ(印刷なし)
- 2026/04/07


持ち替えの手間を減らすシャープペン
ZMA117
179円(税込)
最小発注数100個
芯を出す・文字を書く・消すが片手で完結する、機能性に優れたシャープペンです。振るだけで芯が出せるフリシャ機能搭載で、スムーズな筆記をアシストします。消しゴムは繰り出し式なのでキャップをなくす心配もありません。六角形の軸は鉛筆のように持ちやすく、グリップ部がないため持つ位置を選ばないシームレス設計です。
軸に1色印刷で学校名や企業名を名入れできます。学生から社会人まで使いやすいスタイリッシュなデザインなので、オープンキャンパスのノベルティや学習塾の入会特典、セミナーの参加特典などにおすすめです。


出荷日の目安
- 印刷あり
- 2026/04/22
- 商品のみ(印刷なし)
- 2026/04/07


レジャーで頼れる大容量トートバッグ
U2325870
263円(税込)
最小発注数30個
透け感のある涼しげなデザインが特徴の、大容量肩掛けトートバッグです。レジャーシートのような素材で水や汚れをサッと拭き取れるため、屋外でも気軽に使えます。まとめ買い用のお買い物バッグから、着替えやタオルなどを持ち運ぶレジャーバッグまで幅広いシーンで活躍!底マチが広く自立するので、地面に置いておけるのも便利です。
1色印刷でロゴやブランド名の名入れもできます。レジャー施設のショッパーや、屋外イベントの来場特典のノベルティなどにいかがでしょうか。


出荷日の目安
- 印刷あり
- 2026/04/14
- 商品のみ(印刷なし)
- 2026/04/01


中身が見えるスマート収納ポーチ
LA-8103
807円(税込)
最小発注数30個
中身がひと目で確認できる、クリア素材のラウンドジップポーチです。見開き仕様で一覧しやすく、2ヶ所のポケットと小物を留められる帯できれいに収納できます。ペンケースとしてはもちろん、トラベル用のポーチやガジェット収納にもおすすめ。おしゃれなニュアンスカラーが日常に彩りを添えてくれます。
表面にワンポイントで企業名やロゴの名入れが可能です。実用性とデザイン性を兼ね備えた高品質なアイテムなので、卒業記念品やイベントの物販品などにいかがでしょうか。


出荷日の目安
- 印刷あり
- 2026/04/14
- 商品のみ(印刷なし)
- 2026/04/01


フルカラー印刷で主役級デザイン
TS-1832
1,089円(税込)
最小発注数30個
ワイヤレス充電ができるQi(チー)対応の充電器です。外側はアクリルで、置くだけでパッと目を引くラウンドデザインが特徴。充電時は青いライトが点灯し、アクリルを通して輝きます。充電中もそうでない時も存在感を放つので、社名やロゴを印刷すれば宣伝効果は抜群!
1色またはフルカラー印刷に対応。フルカラーなら透明部にも印刷できます。イラストや写真を自由に配置してオリジナルの記念品を制作してみてはいかがでしょうか。


出荷日の目安
- 印刷あり
- 2026/04/14
- 商品のみ(印刷なし)
- 2026/04/01


広範囲に印刷可能!記念品に最適
H313745
499円(税込)
最小発注数30個
広範囲にプリントできるグラスです。フルカラー印刷は色の濃淡やグラデーションも表現でき、写真やキャラクターのプリントにぴったり!シンプルな1色でも印刷可能です。飲料メーカーの販促品やキャンペーンのノベルティ、飲食店の周年記念品など幅広くご活用いただけます。
飲み物を1杯飲むのにちょうどいい容量で、ビアグラスにもおすすめ。オシャレなカフェ気分が味わえるロング形状です。透け感を楽しめるクリアタイプ、すりガラスのような質感のフロストタイプからお選びください。


出荷日の目安
- 印刷あり
- 2026/04/22
- 商品のみ(印刷なし)
- 2026/04/09


透け感で高級度アップ!
KD237022
108円(税込)
最小発注数30個
上品な透け感が魅力のジッパー付きポーチ。4つ折りのハンカチくらいのサイズ感です。マチ付きで自立します。口紅やマニュキュアなど入れておけるので携帯にとっても便利です。コスメショップの試供品入れや、宿泊施設の洗顔セットなどにもちょうどいいサイズ。名入れ印刷でオリジナルポーチを製作できます。プライベートでも使ってもらえるノベルティで販促効果も抜群!安心の日本製で、メール便で送付できます。


出荷日の目安
- 印刷あり
- 2026/04/14
- 商品のみ(印刷なし)
- 2026/04/01


何度も使えるカイロでSDGsに貢献
TS-1827
220円(税込)
最小発注数30個
リウォームエコカイロ(巾着付)は繰り返し使用が可能なカイロとコットン巾着袋のセット。カイロの液体の中に入っている金属板を押すと、徐々に液体が発熱しながらシャーベット状に広がり温かくなります。使用後はカイロを湯せんをすることで元通りになり、再度使えます。使い捨てにならず環境にもやさしいのでSDGsに貢献できます。コットン素材の巾着付きで、持ち運びも便利なアイテム。
巾着かカイロに会社名やロゴを1色印刷し、オリジナルグッズを作れます。寒い時期に最適なあたたかいノベルティや販促品としておすすめです。


出荷日の目安
- 印刷あり
- 2026/04/14
- 商品のみ(印刷なし)
- 2026/04/01


使う度にうっとりする美しい色合い
RM36060
306円(税込)
最小発注数30個
リノン/オーロラポーチは、光の反射によって色味の変化を楽しめるトレンド感満載のポーチ。ファスナーが底部まで開閉し中身が取り出しやすく便利です。華やかなオーロラカラー生地は光沢があり、中身が見えすぎず上品に使えます。コスメアイテム映えし高級感がアップしますね。
1色印刷が可能です。オーロラポーチに名入れをしてトレンドのオリジナルグッズ製作はいかがでしょうか。美容院やアパレルショップ、エンタメ関係のノベルティ作成におすすめです。


出荷日の目安
- 印刷あり
- 2026/04/14
- 商品のみ(印刷なし)
- 2026/04/01


水や紫外線に強い環境配慮素材
TS-1701
132円(税込)
最小発注数30個
EVAクリアポーチ(S)は、半透明で中身がわかりやすいマチなしのスライダーケース。サラッとした触り心地で、水や紫外線に強いEVA素材です。塩素を含まず焼却してもダイオキシンが発生しないので、環境に配慮したノベルティが製作できます。SDGsの取り組みに貢献できる商品をお探しの方におすすめ。
歯ブラシケースやコスメポーチとして使いやすいサイズ感で、1色かフルカラーで名入れできます。シンプルなフロストボディにブランド名や企業名が映えますよ。キャンペーンの販促品や雑貨店の購入特典にいかがでしょうか。


出荷日の目安
- 印刷あり
- 2026/04/14
- 商品のみ(印刷なし)
- 2026/04/01


手元のカラーで自分の傘が一目瞭然
MARU-90202001
484円(税込)
最小発注数30個
POE60cmクリアジャンプは、焼却しても塩化水素等の有害ガスが発生しない、環境に優しい素材を使用した長傘。ワンタッチで開くジャンプ式なので、使い勝手も抜群。会社や飲食店の傘立てのたくさんのビニール傘から、自分の傘が見つからず苦労していませんか?POE60cmクリアジャンプは手元や露先に色が付いているので、すぐに見つかりストレスフリー!
パネル面に1色印刷が可能です。会社の備品にも大人気のビニール傘。傘に不動産会社のロゴを入れて、物件紹介中の急な雨にお客様への貸し出し用としての製作にオススメです。


出荷日の目安
- 印刷あり
- 2026/04/22
- 商品のみ(印刷なし)
- 2026/04/01


シンプルさが魅力のストレート型
H281143
381円(税込)
最小発注数30個
オーシャンロンググラス(380ml)は飲み物をたっぷりと楽しめる背の高いタンブラーグラス。飽きの来ないシンプルなストレート型です。ソフトドリンクにはもちろん、カクテルやビール、ハイボールなど多様にお使いいただけます。
名入れはワンポイントのパッド印刷・大きなデザインを印刷できる回転シルク印刷が可能。レストランやバーの店舗ロゴを入れた周年記念品・開店記念品にいかがでしょうか。記念品や販促用にピッタリな白無地化粧箱入りです。


出荷日の目安
- 印刷あり
- 2026/04/14
- 商品のみ(印刷なし)
- 2026/04/09


手にフィットする丸み
H227042
411円(税込)
最小発注数30個
ラウンドグラス(330ml)は、手にフィットする丸いフォルムが特徴のアイテム。ベーシック素材のソーダガラスで、デイリーに活躍してくれます。大きめの氷も入れやすいので、オンザロックにもおすすめ。
ドリンクだけでなく、前菜やフルーツの盛り付けにも使えます。パーティーやイベントなどでテーブルが華やかになりますね。
名入れができるので、ロゴを入れればオリジナルのグラスに。記念品にぴったりな白箱でお届けします。包装にも対応しているので、周年記念品や開店記念品に人気です。


出荷日の目安
- 印刷あり
- 2026/04/14
- 商品のみ(印刷なし)
- 2026/04/07


缶のような見た目の映えグラス
H321849
704円(税込)
最小発注数30個
飲料缶のような形状のユニークなグラスです。側面にぐるっとフルカラー印刷ができ、写真やイラストも鮮やかに表現します。インパクトやデザイン性を重視したオリジナルグッズ、同人グッズなどの作成にぴったり!
容量は約460mlと大きめサイズで、花瓶やペン立てなど飾るアイテムとしても活用できます。透け感を楽しめるクリア、すりガラスのような質感が魅力のフロストからお好きな本体色をお選びください。白箱入りで記念品にもおすすめです。


出荷日の目安
- 印刷あり
- 2026/04/14
- 商品のみ(印刷なし)
- 2026/04/01


小ぶりで手になじむサイズ感
MST-24106HS
869円(税込)
最小発注数30個
コロンとした形が手になじんで持ちやすいグラスです。容量はちょっと小ぶりサイズの約275ml。飲みきりにちょうどよい大きさです。お水やカクテルなど、様々な用途でお使いいただけます。
薄めのガラスとしなやかな曲線が織りなす洗練されたデザインで、グッドデザイン賞を受賞。お店のロゴや店名を印刷して、おしゃれなオリジナルグラスを制作できます。


出荷日の目安
- 印刷あり
- 2026/04/14
- 商品のみ(印刷なし)
- 2026/04/07


傷に強い安心品質のシンプルグラス
MST-20106HS
781円(税込)
最小発注数30個
シンプルな形状でさまざまな飲食シーンにマッチするグラスです。安心品質の日本製で、「口部強化加工」により長期間の使用でも傷が付きにくくなっています。口当たりのいいすっきりとした仕上がりです。食洗機対応でお手入れも簡単。容量245mlでお子さまからシニア世代まで手に取りやすいサイズ感です。
シンプルな1色印刷でロゴや店名の名入れができます。飲食店や商業施設、パーティ会場などのドリンク用グラスにいかがでしょうか。


出荷日の目安
- 印刷あり
- 2026/04/14
- 商品のみ(印刷なし)
- 2026/04/07


スタッキング可能でかさばらない
MSCB-02152
363円(税込)
最小発注数30個
多くの飲食店で愛用されている食器用強化ガラスのグラスです。積み重ねができて、スマートに収納可能。口部物理強化加工により優れた耐久性を誇ります。食洗機対応でお手入れも簡単。飲食店やカフェなどのプロフェッショナルなシーンに最適です。
約245mlの程よい容量は、お冷から様々なドリンクまで幅広く対応。1色印刷で店名やロゴを入れて、お店のオリジナルコップとしておすすめです。


出荷日の目安
- 印刷あり
- 2026/04/14
- 商品のみ(印刷なし)
- 2026/04/07


飲食店の定番コップ
MS08310HS
715円(税込)
最小発注数30個
お茶もジュースもアルコールも。レストランやカフェなどプロユース定番のグラスです。ガラスの透明度と純度を向上させ、クリスタルガラスに匹敵するシャープなクリアさを実現。口元はすっきりと厚みのないコールドカット仕上げ。シーンを選ばず使える、シンプルながら洗練されたデザインです。
容量は約315mlと飲み切りに丁度良いサイズ。1色印刷でお店のロゴを入れて、オリジナル感の高いグラスを作成できます。


出荷日の目安
- 印刷あり
- 2026/04/14
- 商品のみ(印刷なし)
- 2026/04/07


人気ボールペンにエコ要素をプラス
ZBI-JJ15
110円(税込)
最小発注数100個
ゼブラの人気シリーズ「サラサ」に、環境に配慮したバイオチューブ搭載モデルが登場。中芯チューブとグリップにサトウキビ由来のバイオマスプラスチックを使用し、CO2排出量を抑えたエコ商品です。サラッとした書き心地はそのままに、地球にもやさしい1本。クリアボディが爽やかで、学生からビジネスパーソンまで幅広く使える定番アイテムです。
軸かクリップに1色印刷で名入れできます。ばらまき向きの激安価格で、展示会やオープンキャンパスで配布するノベルティにぴったり!


出荷日の目安
- 印刷あり
- 2026/04/22
- 商品のみ(印刷なし)
- 2026/04/07


軽くて頑丈な素材のグラス
SW-PC
143円(税込)
最小発注数30個
落としてもガラスのように割れない、ポリカーボネート製の軽量グラスです。容量は約320mlで、飲食店のお冷やドリンク提供にもちょうどよいサイズ感。透明度が高くガラスのような見た目ながら、丈夫で長く使えます。電子レンジ対応なので、温かい飲み物にも便利。
1色印刷で、ワンポイントからぐるっと大きく印刷も可能。飲食店の業務用だけでなく、キャンペーンの景品やオリジナルグッズの作成にもおすすめです。


出荷日の目安
- 印刷あり
- 2026/04/14
- 商品のみ(印刷なし)
- 2026/04/01


持ち運びに便利なフラット形状
LA-8102
477円(税込)
最小発注数30個
かさばりにくいフラット形状でスマートに持ち歩ける、クリアタイプのペンケースです。背面のフラップ付きポケットで、お気に入りの付箋やステッカーを見せながら収納できます。コスメやリップクリームなど、こまごましたアイテムの収納にも便利。日常に彩りを添えるおしゃれなニュアンスカラーが魅力です。
表面にはワンポイントで1色印刷できます。人気文具メーカー「リヒトラブ」の商品は、卒業記念品やオリジナルグッズ制作などにおすすめです。


出荷日の目安
- 印刷あり
- 2026/04/14
- 商品のみ(印刷なし)
- 2026/04/01


テーマに合わせて色を選べる
TP-0043
231円(税込)
最小発注数30個
カラーファスナーとスクエア型が特徴のビニールポーチ。フラットタイプで文庫本などA6サイズが入る大きさです。水に強いPVC素材で、トラベル用にもおすすめ。
表面にはオリジナル印刷が可能。キャラクターやブランドロゴを印刷すればオリジナルティの高いグッズが制作できます。ファスナー部分は、テーマに合わせて選べる豊富なカラー展開!ステーショナリーなど小物やキャラクターグッズを入れたセット販売にもおすすめです。


出荷日の目安
- 印刷あり
- 2026/04/14
- 商品のみ(印刷なし)
- 2026/04/01


推し活コレクションポーチに!
TP-0041
358円(税込)
最小発注数30個
カラフルなメッシュポケットが可愛いビニールポーチ!推しのトレカやアクスタを入れてデコレーションして楽しめます。内側のポケットは標準サイズのトレカを縦・横向きに収納可。ポーチ自体は横長でペンケースとしても使えます。ポーチ外側にはキーホルダーを付けられるループ付き。カラビナを付ければバッグにかけて持ち歩けます。
表面にはオリジナル印刷が可能です。イベントグッズやキャラクターグッズ制作にいかがでしょうか。


出荷日の目安
- 印刷あり
- 2026/04/14
- 商品のみ(印刷なし)
- 2026/04/01


中身が見える便利なビニールポーチ
TP-0042
187円(税込)
最小発注数30個
カラーファスナーがアクセントのスクエア型ビニールポーチ。四つ折りしたミニタオルが収まるサイズ感です。中身が一目でわかるのでアクセサリーや日用品の仕分けポーチに大人気。水に強いPVC素材で、アメニティ入れとしても使えます。
表面にはオリジナル印刷が可能。キャラクターやブランドロゴを印刷すればオリジナルティの高いグッズが制作できます。ファスナー部分は、テーマカラーに合わせて選べる豊富なカラー展開!キャラクターグッズを入れたセット販売にもおすすめです。


出荷日の目安
- 印刷あり
- 2026/04/14
- 商品のみ(印刷なし)
- 2026/04/01


トレカや缶バッチを可愛く持ち歩ける
TP-0040
319円(税込)
最小発注数30個
推しのグッズを可愛く持ち歩ける、カラフルなビニール素材のミニポーチ。内側には標準サイズのトレカが入るメッシュポケット付き。お気に入りのコレクションを入れて、自分だけのデコレーションを楽しめます。カラビナ付きだからバッグやベルトに簡単に取り付けられて便利。豊富な色展開で、キャラクターのイメージカラーに合わせてお選びいただけます。
表面にオリジナル印刷ができるので、イベントグッズやキャラクターグッズ制作にいかがでしょうか。


出荷日の目安
- 印刷あり
- 2026/04/14
- 商品のみ(印刷なし)
- 2026/04/01


スポーツ関連のノベルティにぴったり
TS-1826
539円(税込)
最小発注数30個
500mlのペットボトルより一まわり大きいサイズのボトルです。50ml単位の目盛りで水分量を手軽に管理。シェイカー等の分量目安としても使用可能です。色はクリア、ピンク、ブルー、グリーンの淡い色合いがオシャレな4色展開。ワンポイントまたは大きなサイズでの名入れが可能です。
マイボトルは環境に優しいノベルティとして人気です。スポーツ関連だけでなく雑貨店やアパレルでのノベルティなどにもオススメです。


出荷日の目安
- 印刷あり
- 2026/04/14
- 商品のみ(印刷なし)
- 2026/04/01


写真もイラストも綺麗にプリント
H300646
469円(税込)
最小発注数30個
広範囲に印刷できるシンプルなグラスです。写真やイラストもフルカラーでプリントできます。企業名やロゴにぴったりなワンポイントの1色印刷も可能。オリジナルグッズや周年記念品など様々な用途にお使いいただけるノベルティです。飲食店で提供するお水のグラスにもおすすめ。
容量は約200mlでお子さまも使いやすい小さめサイズ。普段使いに便利な洗いやすい形状です。透け感を楽しめるクリアタイプと、すりガラスのような質感のフロストタイプからお選びください。


出荷日の目安
- 印刷あり
- 2026/04/22
- 商品のみ(印刷なし)
- 2026/04/09


100円以下の驚き激安価格
TF-0130
33円(税込)
最小発注数30個
ノック式の定番ボールペンです。名入れは軸に1色印刷に対応。商品価格も印刷代もリーズナブルで、30個から注文可能です。とにかく安く大量にノベルティを作りたいばらまき営業や、展示会などに活躍すること間違いなし!素材には廃プラスチックを再利用し、環境に考慮した企業アピールにも役立ちますよ。


出荷日の目安
- 印刷あり
- 2026/04/14
- 商品のみ(印刷なし)
- 2026/04/01


半透明の爽やかマイボトル
KD241331
405円(税込)
最小発注数30個
半透明のフロストのような風合いがおしゃれなボトル。目盛りつきで、毎日の水分摂取量の目安がわかり便利です。樹脂製の本体はとても軽く、持ち運びに便利なストラップ付き。お出掛けにちょうど良いサイズ感です。
1色での印刷が可能です。スポーツジムの入会特典や野外フェスのオリジナルグッズなど、オリジナルマイボトルが制作できます。


出荷日の目安
- 印刷あり
- 2026/04/14
- 商品のみ(印刷なし)
- 2026/04/01


上品な透け感が魅力!
KD237023
141円(税込)
最小発注数30個
透け感のある梨地クリアビニール素材。マチ付きで自立する横長ポーチです。コスメやガジェットなど小物を整理できてとっても便利です。高級感があるのでコスメショップの試供品入れや、宿泊施設のアメニティセットなどにもオススメです。名入れ印刷でオリジナルポーチを製作できます。プライベートでも使ってもらえるノベルティで販促効果も抜群!安心の日本製で、メール便で送付できます。


出荷日の目安
- 印刷あり
- 2026/04/14
- 商品のみ(印刷なし)
- 2026/04/01


おしゃれに見せる自立型透明ポーチ
KD231010
273円(税込)
最小発注数30個
ピュアナ・クリアスクエアポーチは透明感あるスクエア型ポーチ。PVC素材なので水濡れに強く、柔らかく丈夫。ファスナーには可愛いチャーム付きでコンパクトながらもマチ付きで収納力もあります。透明度が高いので中身が綺麗に見えて高見えします。スキンケア収納や旅行先にはもちろん、自立可能なのでお気に入りのコスメグッズや雑貨を入れてお部屋にディスプレイしても可愛いですね。
メール便対応サイズなのでDMと一緒に送付可能。1色でロゴ印刷して美容、コスメのキャンペーンのノベルティ作製はいかがでしょうか。


出荷日の目安
- 印刷あり
- 2026/04/14
- 商品のみ(印刷なし)
- 2026/04/01


思わず自慢したくなるかっこよさ
TS-1370
495円(税込)
最小発注数30個
フレームスクエアボトルは、香水瓶のようなスクエア型のフォルムが新しいウォーターボトルです。フラットなボトル形状で、オリジナル印刷の範囲が広くSNS映えも確実!1色またはフルカラー印刷が可能。フレームの色は豊富なカラーバリエーションから選べます。デザインとフレームの色を合わせた「推し色」グッズの制作や、ライブグッズにもおすすめ。
ドリンクを入れてスポーツやお出かけに持って行くのはもちろん、ご自宅用として洗剤やシャンプー・リンスを入れるのにも使えます。自作のハーバリウムを作ってインテリアにしても可愛いですよ。フレームは分解できるため、お手入れも簡単!使い勝手の良さとデザインを両立した、オリジナルボトルが製作できます。


出荷日の目安
- 印刷あり
- 2026/04/14
- 商品のみ(印刷なし)
- 2026/04/01


透明なので文字を隠せず読める
NES3088
106円(税込)
最小発注数30個
パステルフィルム付箋(大)は、ピッとつまんで取り出せるピックアップ式付箋。スーツの胸ポケットにも入る、スリムで携帯しやすいプラケースに、5色2サイズのフィルム付箋をセットしました。用途ごとに付箋の色を使い分けすれば必要な個所がすぐに見つかりますね。
透けて見える透明タイプだから、付箋を貼った箇所に文字が掛かっても安心。付箋がジャマで貼り直すなんて面倒な手間もなくなりますよ!


出荷日の目安
- 印刷あり
- 2026/04/14
- 商品のみ(印刷なし)
- 2026/04/01


なめらかインキ搭載のクリップ版!
ぺんてる ビクーニャフィール ワイドオープンクリップ 0.7mm
PEBXB117
84円(税込)
最小発注数100個
ぺんてる ビクーニャフィール ワイドオープンクリップ 0.7mmは油性ペンながらもなめらかな書き味が魅力のビクーニャインキを搭載。書き始めのカスレはほぼゼロ!ゲルインキに匹敵する軽い書き心地です。
クリップは厚みのあるノートやバインダーに挟んで使える丈夫なコイルスプリング式を採用しています。グリップ部は24面カットにすることで、指にフィットするポジションを探しやすくしています。
ボールペンの質の良さを体感してもらうため設計されたボディは、すっきりシンプルなデザインです。企業名やロゴなどで名入れ印刷をすれば販促効果はバッチリ。営業配布や展示会、説明会での配布ノベルティにいかがでしょうか。


出荷日の目安
- 印刷あり
- 2026/04/22
- 商品のみ(印刷なし)
- 2026/04/07


ホット・アイス両用の耐熱二重構造
KD225033
768円(税込)
最小発注数30個
ブランジェリー メール・耐熱ダブルウォールグラス2Pセットはホットもアイスも楽しめるグラスの2個セット。二重構造のため、中身の温度が手に伝わりにくいのでホットでも安心。結露もしにくくテーブルを汚しません。
コロンと丸いフォルムや飲み物が宙に浮いたように見えるデザインが人気のダブルウォールグラス。容量は約200mlサイズで、ちょっとしたティータイムにぴったり。ドリンクだけでなくデザートカップとしても使えます。1色での名入れ印刷が可能なので、レストランやカフェの店名ロゴを入れた周年記念品制作にいかがでしょうか。


出荷日の目安
- 印刷あり
- 2026/04/14
- 商品のみ(印刷なし)
- 2026/04/01


大きくフルカラープリントOK!
H165948
528円(税込)
最小発注数30個
「昇華転写対応グラスマグ(300ml)クリア」は、クリアタイプのガラス製マグ。持ち手が広く、飲みやすいデザインのマグカップです。容量約300mlのちょうど良いサイズのマグは、オフィスやリビングで飲み物を楽しむのにぴったりです。ガラス製で本体自体がどっしりと重量感があるので、ちょっとぶつかった位で倒れる心配もありません。
フルカラーの名入れはもちろん、写真やグラデーションも再現可能。ガラスの透明感を活かして、真っ白な陶器製マグとは違ったデザインに仕上げられます。


出荷日の目安
- 印刷あり
- 2026/04/22
- 商品のみ(印刷なし)
- 2026/04/09


たっぷり飲める大容量ビアグラス
H190940
352円(税込)
最小発注数30個
デカビアグラス 420ml(クリア)は泡を含めた350mlのビール缶1本分が入る大容量のビアグラス。飲み口が広く持ちやすい形状で、ビール以外のソフトドリンク用としてもおススメです。
名入れが映えるシンプルなデザイン。グラスの側面にパッド1色でワンポイント印刷できます。ロゴを印刷してオリジナルのビアグラスの作成に。飲食店のオリジナルグラスや、企業の周年記念品、ファンクラブグッズなど幅広いシーンで人気です。


出荷日の目安
- 印刷あり
- 2026/04/14
- 商品のみ(印刷なし)
- 2026/04/09


ペン先をスマートに収納
ZB3A3
262円(税込)
最小発注数100個
ゼブラ クリップ-オンG 3C 0.7mmは黒、赤、青3色の多色ペン。ペン先を素早く収納できるスマートノック解除機能付きです。ペンを持ち変えずに本体中央のボタンを押すだけでペン先が収納できるのでとっても便利。
インクは滲みに強く、耐水性に優れている油性インクを採用。油性インクは速乾性も高く耐光性にも優れているので、長期間保存される文書の使用におすすめです。クリップは挟める可動式バインダークリップ。ノートに挟めるのはもちろん、バッグの中のポケットにも挟めるので使いたいときにペンがないのを防げます。
本体側面に1色印刷、白軸のみフルカラー印刷(白軸のみ)が可能です。ロゴや社名を名入れしてセミナーのノベルティに人気です。


出荷日の目安
- 印刷あり
- 2026/04/22
- 商品のみ(印刷なし)
- 2026/04/07


プチギフトにぴったりの小瓶入り!
AW-sugarbottle
印刷代込み 719円(税込)~
最小発注数100個
プチ角瓶(金平糖入り)は、プチサイズの瓶にキラキラかわいい金平糖が入ったお菓子ノベルティ。瓶本体にフルカラーで印刷が可能です。金平糖は選べる全7種類。瓶は透明なので、中身の金平糖とデザインの色味を合わせてもおしゃれですね。食べてもおいしい、そのまま飾ってもかわいい瓶入りのお菓子は、レジャー施設やイベントのオリジナルグッズとして人気です。金平糖を食べ終わった後も小物入れとして使えます。


出荷日の目安
- 印刷あり
- 2026/04/27
- 商品のみ(印刷なし)


中身が見えて文具の取り出しが楽!
LA-8100
499円(税込)
最小発注数30個
リヒトラブ soeru クリヤーペンケースは、中の文具が確認しやすい透明タイプの筆箱で、取り出しがラクラク!おしゃれな色付きの内ポケットには、小物を分けて入れられます。側面のリングは、キーホルダーを付けることができます。
暮らしに彩りを“そえる”文具メーカーLIHIT LAB.(リヒトラブ)の商品。耐久性があり軽量なPVC素材を使用。スリムなマチ付きでペンは約20本入ります。
1色名入れ印刷をすれば、オリジナルペンケースが作れます。セミナーやオープンキャンパスにおすすめのノベルティです。
動画提供 : リヒトラブ【公式】


出荷日の目安
- 印刷あり
- 2026/04/14
- 商品のみ(印刷なし)
- 2026/04/01


人気のクリアフタ付きタンブラー
TS-1426
688円(税込)
最小発注数30個
ウォールカラーステンレスタンブラーは、ステンレス2重構造のクリア蓋付きタンブラーです。本体色クリアは流行を意識したデザインで、内側のステンレスがあえて見える造りになっています。
クリア素材が「抜け感」を醸し出すおしゃれな構造なので、毎日使いたくなるこのウォールカラーステンレスタンブラー。ステンレス2層構造は結露も気にならず、クリアの蓋はあけなくて中身が確認できるので、デスク周りでも活躍します。
広範囲にぐるっと印刷できる回転シルク印刷の名入れにも対応しています。企業ロゴを印刷してノベルティやキャンペーンの販促品にするなど、オリジナルタンブラー作りにおすすめです。


出荷日の目安
- 印刷あり
- 2026/04/14
- 商品のみ(印刷なし)
- 2026/04/01


フルーツやサラダの持ち運びに
NEC3801
411円(税込)
最小発注数30個
手のひらサイズのかわいいフードコンテナです。蓋に取外し可能な保冷剤付きだからお出かけ前に凍らせてセットするだけ!ランチ等に気軽に持ち運べます。側面には目盛が付いているのも嬉しいポイントです。手作りのドレッシングを作る時などに便利ですよ。
蓋に1色ロゴ印刷ができます。雑貨店のオリジナルグッズ製作などにおススメです。


出荷日の目安
- 印刷あり
- 2026/04/14
- 商品のみ(印刷なし)
- 2026/04/01


遊び心あるユニークな形状
H288142
425円(税込)
最小発注数30個
飲料缶をモチーフにした、思わず手に取りたくなるユニークなグラスです。飲み切りやすい約360mlで、日常使いにちょうどいいサイズ感。透明感を活かして飲み物の色合いも楽しめます。花瓶や小物入れなどインテリアグッズとして使えるのも魅力です。
側面にはワンポイントかぐるっと広範囲に1色印刷できます。ロゴやオリジナルデザインなどを入れたグッズ作成にぴったり!飲料メーカーのノベルティや、アーティストのファンクラブグッズなどにおすすめです。


出荷日の目安
- 印刷あり
- 2026/04/14
- 商品のみ(印刷なし)
- 2026/04/01


ユニーク形状で映えるグラス
H288241
440円(税込)
最小発注数30個
飲料缶のようなユニークな形状が目を引く、遊び心のあるグラスです。ロング缶と同程度の約490mlで、お酒やソフトドリンクをたっぷり楽しめます。透明なので飲み物の色合いもきれいに映えるのが魅力。花瓶やペン立てなどインテリア雑貨としても使えます。
側面に1色印刷が可能で、ロゴやオリジナルデザインを入れたグッズ作成にぴったり。おうち時間を彩るアイテムとして幅広い世代に喜ばれます。飲料メーカーのノベルティや、アーティストのファンクラブグッズなどにいかがでしょうか。


出荷日の目安
- 印刷あり
- 2026/04/14
- 商品のみ(印刷なし)
- 2026/04/01


大人に贈る至高のロックグラス
U2376791
296円(税込)
最小発注数36個
重厚感のある佇まいのロックグラスです。表面に市松の凹凸が施され、シンプルながらも飽きのこないデザインが魅力。手にも馴染みやすい形状です。容量約280mlで、ウイスキーや焼酎をゆったり楽しむのにぴったり。
リッチなおうち時間を演出する一品として、大人の方への贈り物におすすめです。金融・保険企業の成約ノベルティや飲食店の記念品など、幅広いシーンにご活用いただけます。高級感のあるゴールドの化粧箱に入れてのお届けです。


出荷日の目安
- 印刷あり
- 商品のみ(印刷なし)
- 2026/04/01


高級感のあるゴールドの化粧箱入り
U2376801
439円(税込)
最小発注数36個
重厚感のあるロックグラスが2つ入ったギフト商品です。容量約280mlで、ウイスキーや焼酎をゆったり楽しめます。表面に市松の凹凸が施され、シンプルながらも飽きのこないデザインが魅力。手にも馴染みやすい形状です。高級感のあるゴールドの化粧箱入りでお届けします。
大人のおうち時間を格上げするリッチなアイテムなので、金融・保険企業の成約記念品や飲食店の周年記念品などにおすすめ。包装にも対応しています。


出荷日の目安
- 印刷あり
- 商品のみ(印刷なし)
- 2026/04/01


ケーキやサラダ用に
H288647
616円(税込)
最小発注数30個
シンプルさが魅力のガラス製平皿。ケーキ皿やサラダの盛り付けにちょうどいい直径15cmサイズで、日常使いはもちろん来客時にも活躍します。透明感のあるクリアガラスが食材の色味を美しく引き立て、盛り付けをすっきりと見せてくれるのも特長。主張しすぎないデザインのため、テーブルコーディネートの雰囲気を選ばず、和・洋・中さまざまな料理に自然になじみます。重ねて収納でき、省スペースで保管できる点も嬉しいポイントです。


出荷日の目安
- 印刷あり
- 商品のみ(印刷なし)
- 2026/04/07


フルーツの盛り付けやディスプレイに
H288548
601円(税込)
最小発注数30個
シンプルなガラス製のクリアプレート。デザートやフルーツの盛り付けにちょうどいい直径12cmサイズ。日常使いから来客時まで幅広く活躍します。透明感のあるガラス素材が料理やスイーツの色合いを引き立て、和・洋・中を問わずさまざまなシーンに自然となじみます。重ねて収納できるため省スペースで保管できるのも嬉しいポイント。アクセサリーや小物のディスプレイ用としてもおすすめです。


出荷日の目安
- 印刷あり
- 商品のみ(印刷なし)
- 2026/04/07


4種類のふせんを薄型ケースに収納
MCST161
251円(税込)
最小発注数30個
思いついたアイデアをすぐにメモできるケース入ふせんセット。4種類のふせんがケースに収まっており、持ち運びにも便利。鞄の中でかさばらず、ふせんがバラつく心配もありません。透明ケースで中身が見えるから、デスク上で必要なふせんをサッと取り出せます。
1色のパッド印刷と大きく名入れ可能なシルク印刷・インクジェット印刷に対応しています。セミナーやイベントのノベルティ、塾の入会特典、学校説明会などにいかがでしょうか。


出荷日の目安
- 印刷あり
- 2026/04/14
- 商品のみ(印刷なし)
- 2026/04/01


手のひらサイズのアクリルグッズ
EC-acmg-40
印刷代込み 137円(税込)~
最小発注数50個
厚みのあるアクリル素材の透明感が魅力のマグネットです。イラストや写真をフルカラーで印刷でき、お手頃価格でオリジナルグッズが作成できます。しっかりくっつくネオジウム磁石で、実用性も抜群です。
かわいらしい手のひらサイズで、お子さまから大人まで幅広い年齢層の方に喜ばれますよ。ショップのオリジナルグッズや同人グッズ、飲食店のロゴを印刷したオープン記念品などにいかがでしょうか。丸型・四角型からお好きな形状をお選びいただけます。


出荷日の目安
- 印刷あり
- 2026/04/22
- 商品のみ(印刷なし)


単行本サイズでインパクト抜群!
H316654
印刷代込み 2,967円(税込)~
最小発注数20個
フルカラー印刷できる美麗なアクリルブロックです。片面または両面に印刷できます。表面と背面で異なるデザインを入れられ、奥行きのある仕上がりに。小説の単行本と同じくらいのサイズでインパクト抜群!フチは面取りされていて、なめらかな仕上がりです。
印刷は縦向きにも横向きにも対応しています。イラストや写真を活かして、スポーツチームやアーティストの物販品、美術展や原画展のオリジナルグッズなどにいかがでしょうか。重厚感があるので、企業の周年記念品や竣工記念品などにもおすすめです。


出荷日の目安
- 印刷あり
- 2026/04/22
- 商品のみ(印刷なし)


奥行き感を表現できるアクリルグッズ
H316456
印刷代込み 1,925円(税込)~
最小発注数20個
イラストや写真をフルカラーで印刷し、そのまま立てて飾れるアクリルブロックです。片面または両面に印刷できます。表面と背面で別々のデザインにして、奥行きのある表現も可能です。L判写真サイズで卓上にも飾りやすくなっています。フチは面取りされており、厚み20mmの重厚感がありながらもやわらかな印象です。
アーティストやキャラクターを印刷すれば、推しをいつでも眺められるファングッズに。高級感があるので、会社のロゴを入れた周年記念品や竣工記念品にもおすすめです。


出荷日の目安
- 印刷あり
- 2026/04/22
- 商品のみ(印刷なし)


両面印刷でデザインの幅が広がる
H316555
印刷代込み 2,189円(税込)~
最小発注数20個
表面と背面で異なるデザインをフルカラー印刷できるアクリルブロックです。片面または両面に印刷でき、奥行きのある仕上がりでデザインの幅が広がります。文庫本と同じくらいのサイズ感でインパクト抜群!縦向きでも横向きでもそのまま飾れます。フチが面取りされていてなめらかなので、インテリアにもなじみやすいです。
印刷面が広く、エンタメ系のオリジナルグッズや同人グッズなどにぴったりです。白箱入りなので、企業ロゴや写真を印刷した周年記念品や竣工記念品としてもご活用いただけます。


出荷日の目安
- 印刷あり
- 2026/04/22
- 商品のみ(印刷なし)


重厚感あるカットデザインが魅力
M36109
273円(税込)
最小発注数30個
カットラインが美しいエレガントな雰囲気のロックグラスです。カット面は持ちやすく落下防止の役目もあります。 容量は290mlで日常的な飲み物を入れるのにちょうどよい大きさ。氷を入れてウイスキーを楽しんだり、水やソーダで割ってハイボールにもおすすめです。
上品なギフトボックス入り。カフェやバーなど飲食関係での周年記念品や開店記念のプレゼントにおすすめです。


出荷日の目安
- 印刷あり
- 商品のみ(印刷なし)
- 2026/04/01


缶ジュースサイズで使い勝手抜群
MST-24104HS
957円(税込)
最小発注数30個
薄めのガラスと曲線が美しいグッドデザイン賞受賞のグラス。コロンと丸いフォルムがしっくり手になじみます。容量は缶ジュースサイズの約360ml。アレンジコーヒーやビール、カクテルなど幅広くお使いいただけます。
1色印刷で名入れが可能。お店のロゴを入れて、カフェやビストロなどのオリジナルグラスにぴったりです。


出荷日の目安
- 印刷あり
- 2026/04/14
- 商品のみ(印刷なし)
- 2026/04/07


たっぷり飲める大きめサイズ
MST-24102HS
1,034円(税込)
最小発注数30個
たっぷり容量約490mlのグラスです。コロンと丸いフォルムで大き目ながら手になじみやすい。ガラスが薄く軽やかなフォルムが特徴です。シンプルながら洗練されたデザインでグッドデザイン賞を受賞しています。
果実いっぱいのアレンジティーやスムージーなど流行りのドリンクが映えます。ロゴや店名を印刷すれば、素敵なオリジナルグラスの完成です。


出荷日の目安
- 印刷あり
- 2026/04/14
- 商品のみ(印刷なし)
- 2026/04/07


強化ガラス使用で耐久性アップ
MST-21102HS
792円(税込)
最小発注数30個
「口部強化加工」により、長期間使用しても傷が付きにくいシンプルなグラスです。なめらかな口当たりの仕上がりで、飲み物をしっかり味わえます。氷を入れてもちょうどいい容量305mlです。食洗機対応でお手入れも簡単。幅広い年代の人が使いやすく実用性の高い日本製の商品です。
ワンポイントか広範囲に1色印刷が可能で、ロゴや施設名を入れたオリジナルグラスが作成できます。カフェやバーのドリンク用、宿泊施設の備え付け用などにおすすめです。


出荷日の目安
- 印刷あり
- 2026/04/14
- 商品のみ(印刷なし)
- 2026/04/07


手に馴染みやすいストレート型
MS08309HS
715円(税込)
最小発注数30個
満水量235mlのオンザロックグラス。ウイスキーや焼酎、梅酒などにぴったり。手にしたときにずっしりと重厚感があり、提供するドリンクに高級感が出ます。安心の日本製でバーなど飲食店の業務用グラスに人気の商品です。
口部を厚くする加工が施されており耐久性は抜群。コールドカットですっきりとした口当たりに仕上がっています。お店のロゴを入れてオリジナルグラス制作にいかがでしょうか。


出荷日の目安
- 印刷あり
- 2026/04/14
- 商品のみ(印刷なし)
- 2026/04/07


ちょっと飲みたいにちょうどいい
MS08305HS
660円(税込)
最小発注数30個
レストランや宴会場などプロユース定番グラスの、小さめサイズです。容量約150ml。乾杯グラスとしてだけでなく、試飲会イベントなどにもおすすめ。美しく、丈夫な「ファインクリア」ガラスを使用しており、食洗器対応です。口元はすっきりと厚みのないコールドカット仕上げ。シンプルながら洗練されたデザインで、シーンを選ばず使えます。
1色印刷で店名やロゴを入れて、オリジナルグラスの制作はいかがですか。


出荷日の目安
- 印刷あり
- 2026/04/14
- 商品のみ(印刷なし)
- 2026/04/07


飲食店や宴会場での定番グラス
MS08308HS
693円(税込)
最小発注数30個
カフェやレストランでの定番グラスです。瓶飲料のお供や、水やお茶のサーブにぴったりの容量約240ml。美しく、丈夫な「ファインクリア」ガラスを使用しており、食洗器対応です。口元はすっきりと厚みのないコールドカット仕上げ。シンプルながら洗練されたデザインで、シーンを選ばず使えます。
ロゴや店名を印刷して、オリジナルグラスが作成できます。ぐるっと大きく印刷もできるので、デザインで遊ぶこともできますよ。


出荷日の目安
- 印刷あり
- 2026/04/14
- 商品のみ(印刷なし)
- 2026/04/07


みんな知ってるあのコップ
MS00345HS
330円(税込)
最小発注数30個
スタッキング可能なガラスコップ。どこかで見たことがある、飲食店定番のデザインです。美しく、丈夫な「ファインクリア」ガラスを使用。長年にわたり愛されてきた定番グラスとして、ロングライフデザイン賞を受賞しています。食洗器対応でお手入れが簡単なのがうれしい。
容量約200mlは、お冷やお茶を入れるのにちょうどよいサイズ。1色印刷で名入れができます。細部までこだわったお店作りに、ロゴや店名を入れたオリジナルコップの作成はいかがですか。


出荷日の目安
- 印刷あり
- 2026/04/14
- 商品のみ(印刷なし)
- 2026/04/07


オンザロックと言えばこれ
MST-20105HS
737円(税込)
最小発注数30個
満水量220mlのオールド・ファッションド・グラス。丸削りのロックアイスが入る広口タイプで、ウイスキーやショート・ドリンクにぴったり。手にしたときにずっしりと重厚感があり、提供するドリンクに高級感が出ます。安心の日本製でバーなど飲食店の業務用グラスに人気の商品です。
口部を厚くする加工が施されており耐久性は抜群。業務用食洗器にも対応可能です。コールドカットですっきりとした口当たりに仕上がっています。お店のロゴを入れてオリジナルグラス制作にいかがでしょうか。


出荷日の目安
- 印刷あり
- 2026/04/14
- 商品のみ(印刷なし)
- 2026/04/07

本体カラーで探すをカテゴリから探す

ご注文の流れ
納期は商品や印刷方法により異なりますので、各商品ページでご確認ください
注文・
デザイン入稿
STEP1注文・
デザイン入稿

下記の方法でご注文・デザイン入稿ください。
- 注文フォーム(商品ページ)
- 担当者にメール
- FAX送付

ご入金 STEP2ご入金

ご注文から翌営業日中に請求書をお送りいたします。銀行振込でお支払いください。ご入金確認後の進行となります。

デザイン確認
(画像校正)
STEP3デザイン確認

デザイン入稿後、印刷のイメージ画像を作成しお送りします。OKのお返事を頂いてから印刷を開始いたします。

注文 STEP1注文

下記の方法でご注文ください。
- 注文フォーム(商品ページ)
- 担当者にメール
- FAX送付

ご入金 STEP2ご入金

ご注文から翌営業日中に請求書をお送りいたします。銀行振込でお支払いください。ご入金確認後の進行となります。

在庫は変動いたしますので、
ご注文前に在庫のご確認をお願いいたします。
デザイン事例
株式会社イディアスについて
「ほしい!ノベルティ」は、株式会社イディアスが運営しているサイトです。
自分たちがもらったら「うれしい!」と思えるようなデザイン性が高くおしゃれな商品選びを中心に、私たちならではの商品情報を提供できるようにいつも心掛けています。





スタッフ体験レビュー / 商品開発秘話
「ほしい!ノベルティ」では、スタッフが実際に商品を使用して詳細なレビューを提供しています。
メーカーとの密接な連携により製品改善にも貢献。また、開発秘話の取材や正直な評価を通じて、商品の背景にある物語や価値をお客様に伝えています。スタッフ、メーカー、印刷所の三者が一体となって、より良い商品とサービスの追求を目指しています。


 人気
人気 新着順
新着順 おすすめ順
おすすめ順 安い順
安い順 高い順
高い順